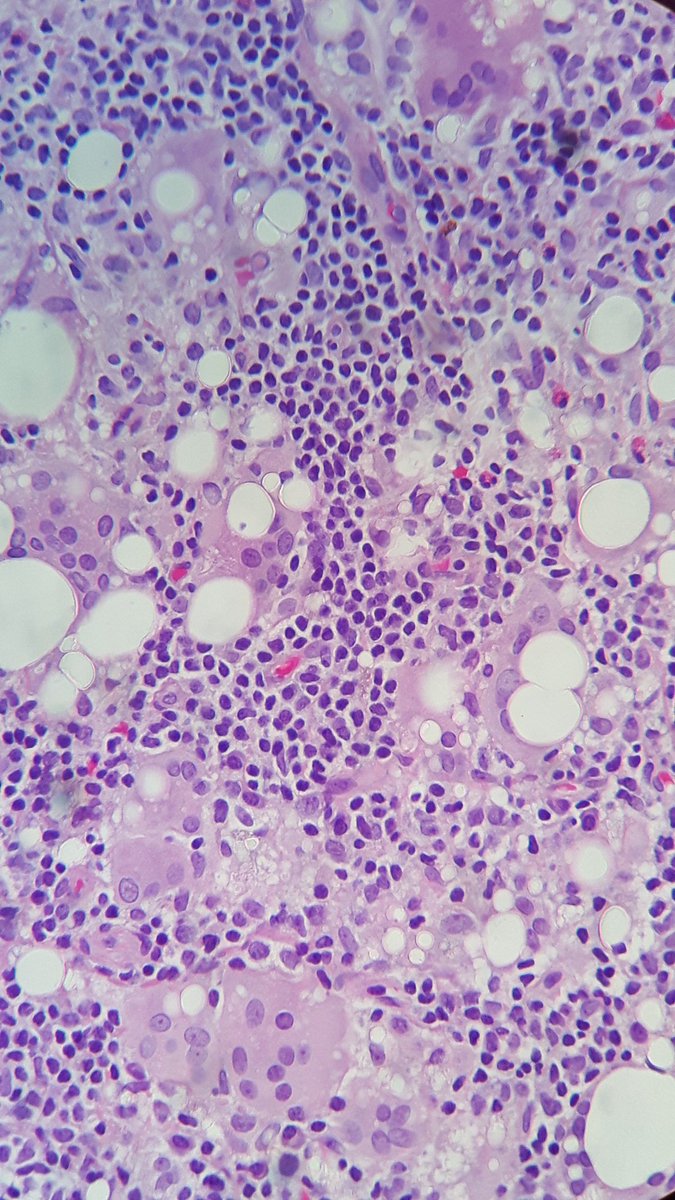
Micropics for all the  #pathtcuriosus &  @ariella8

axilar lymph node. When you cut it, translucent & sticky material. Your guess? #grossognosis @SEAP_IAP
axilar lymph node. When you cut it, translucent & sticky material. Your guess? #grossognosis @SEAP_IAP
 axilar lymph node. When you cut it, translucent & sticky material. Your guess? #grossognosis @SEAP_IAP
axilar lymph node. When you cut it, translucent & sticky material. Your guess? #grossognosis @SEAP_IAP

 Read on Twitter
Read on Twitter